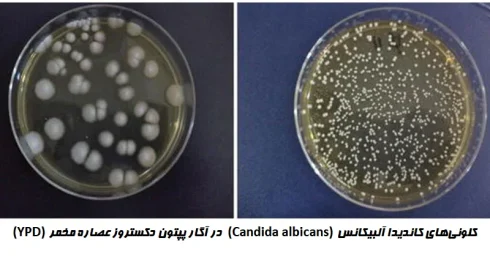
آگار YEPD
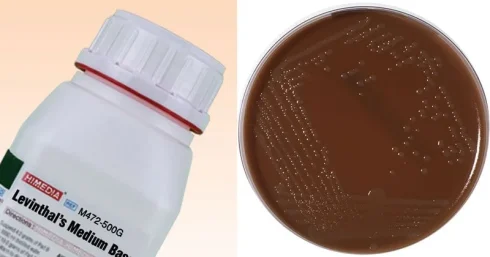
محیط کشت لوینتال
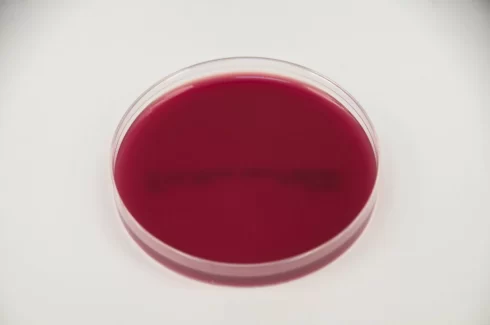
بلاد آگار بی‌هوازی
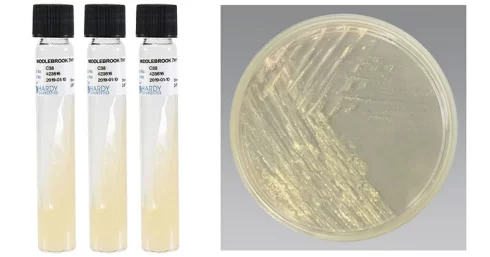
محیط کشت میدلبروک آگار
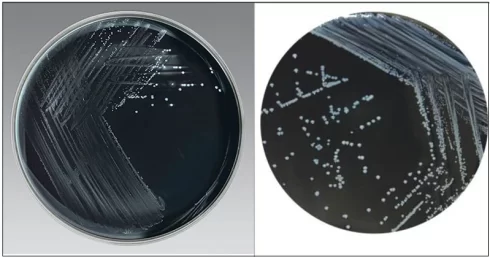
محیط کشت انتخابی زغال چوب
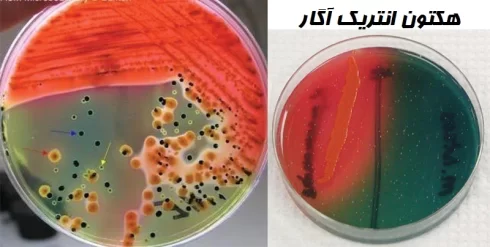
هکتون انتریک آگار
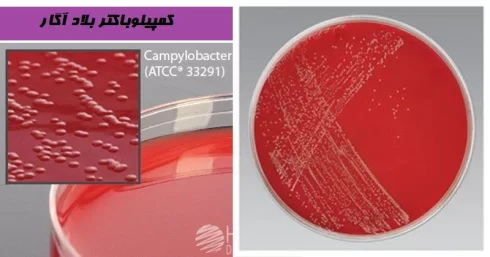
محیط کشت CVA
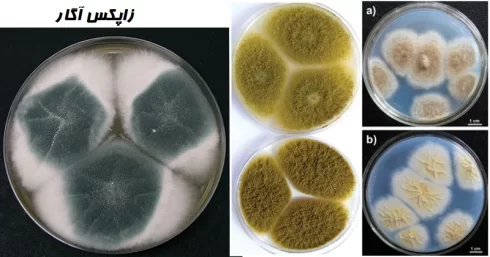
زاپکس آگار
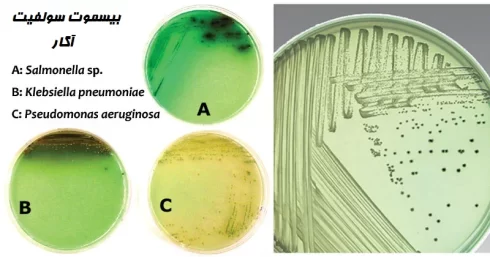
محیط کشت BSA
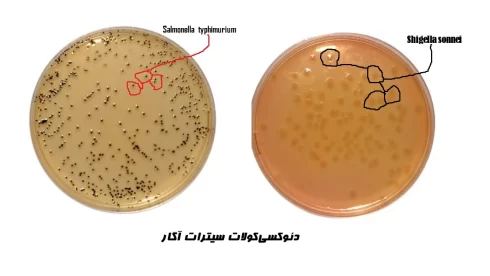
محیط کشت DCA
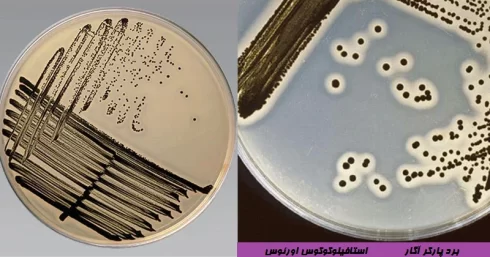
برد پارکر آگار
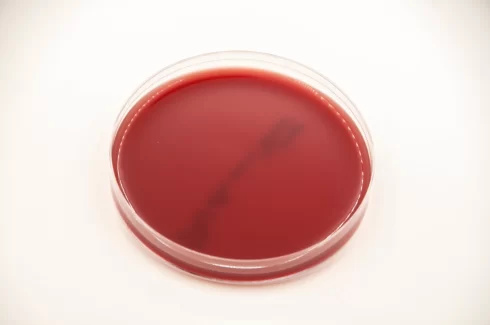
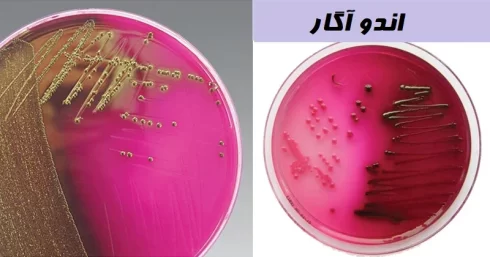
اندو آگار (Endo Agar): ترکیب، اصول، روش آماده‌سازی و کاربرد

آرشیو دسته بندی: ابزار و وسایل آزمایشگاهی شامل، محلول ها کیت ها
آگار YEPD: ترکیب، اصول، آمادهسازی، نتایج و موارد استفاده
مخمرها، یوکاریوتهای (Eukaryote) تک سلولی هستند و در ژنتیک مولکولی به طور گسترده مورد مطالعه[بیشتر بخوانید]
2 دیدگاه
محیط کشت لوینتال (Levinthal’s Medium): ترکیب، اصول، روش آمادهسازی، نتایج و موارد استفاده
مقدمهای بر محیط کشت لوینتال محیط کشت لوینتال برای کشت گونههای هموفیلوس (Haemophilus) استفاده میشود.[بیشتر بخوانید]
DNA لدر چیست؟ انواع و موارد استفاده
تعریف DNA لدر DNA لدر محلولی از مولکولهای DNA با طولهای مختلف است که در[بیشتر بخوانید]
پتری دیش چیست؟ تعریف، قطعات، انواع، موارد استفاده
پتری دیش یک ظرف شفاف کم عمق کوچک به همراه درب است که عمدتاً در[بیشتر بخوانید]
محیط کشت لون اشتاین جانسون (LJ): ترکیب، اصول، روش آمادهسازی، نتایج و موارد استفاده
مقدمهای بر محیط کشت لون اشتاین جانسون محیط کشت لون اشتاین جانسون یک محیط انتخابی[بیشتر بخوانید]
محیط کشت لوفلر (Loeffler Medium): ترکیب، اصول، روش آمادهسازی، نتایج و موارد استفاده
مقدمهای بر محیط کشت لوفلر محیط کشت لوفلر اصلاحی بر روی فرمول اصلی محیطی است[بیشتر بخوانید]
تایر مارتین آگار اصلاح شده (Modified Thayer Martin Agar): ترکیب، اصول، روش آمادهسازی، نتایج و موارد استفاده
مقدمهای بر تایر مارتین آگار اصلاح شده Thayer و Martin یک بهبود در فرمول شکلات[بیشتر بخوانید]
بلاد آگار بیهوازی (Anaerobic Blood Agar): ترکیب، اصول، روش آمادهسازی، نتایج و موارد استفاده
مقدمهای بر بلاد آگار بیهوازی بلاد آگار بیهوازی یک محیط کشت جامد است که جهت[بیشتر بخوانید]
میدلبروک آگار (Middlebrook Agar): ترکیب، اصول، روش آمادهسازی، نتایج و موارد استفاده
مقدمهای بر میدلبروک آگار محیطهای کشت زیادی برای کشت مایکوباکتری در طول سالها ابداع شده[بیشتر بخوانید]
محیط کشت انتخابی زغال چوب (Charcoal Selective Medium): ترکیب، اصول، روش آمادهسازی، نتایج و موارد استفاده
مقدمهای بر محیط کشت انتخابی زغال چوب در سال 1984، Bolton و همکارانش اظهار داشتند[بیشتر بخوانید]
محیط کشت هارت اینفیوژن آگار (Heart Infusion Agar): ترکیب، اصول، روش آمادهسازی، نتایج و موارد استفاده
مقدمهای بر محیط کشت محیط کشت هارت اینفیوژن آگار ارگانیسمهای سختپسند (Fastidious) که نیازهای غذایی[بیشتر بخوانید]
هکتون انتریک آگار (محیط کشت HE): ترکیب، اصول، آمادهسازی و نتایج
هکتون انتریک آگار یک محیط انتخابی و افتراقی است که برای جداسازی و افتراق گونههای[بیشتر بخوانید]
محیط کشت CVA (کمپیلوباکتر بلاد آگار): ترکیب، اصول، آمادهسازی، نتایج و کاربرد
مقدمهای بر محیط کشت CVA (کمپیلوباکتر بلاد آگار) کمپیلوباکتر بلاد آگار یک محیط انتخابی است[بیشتر بخوانید]
زاپکس آگار (محیط کشت CZA): ترکیب، اصول، آمادهسازی، نتایج و کاربرد
مقدمهای بر زاپکس آگار محیط کشت زاپکس، همچنین به نام زاپکس آگار یا زاپکس داکس[بیشتر بخوانید]
محیط کشت BSA: ترکیب، اصول، آمادهسازی، نتایج و کاربرد
مقدمهای بر محیط کشت BSA (بیسموت سولفیت آگار) باکتریهای سالمونلا (Salmonellae) از نظر طبقهبندی پیچیدهترین[بیشتر بخوانید]
محیط کشت DCA: ترکیب، اصول، روش آمادهسازی، نتایج و کاربرد
مقدمهای بر محیط کشت DCA محیط کشت DCA (دئوکسیکولات سیترات آگار) با اصلاح فرمول محیط[بیشتر بخوانید]
برد پارکر آگار (Baird Parker Agar): ترکیب، اصول،آمادهسازی، نتایج و کاربرد
مقدمهای بر برد پارکر آگار برد پارکر آگار توسط Baird Parker با استفاده از فرمولاسیون[بیشتر بخوانید]
2 دیدگاه
اشدون آگار (Ashdown’s Agar): ترکیب، اصول، آمادهسازی، نتایج و کاربرد
مقدمهای بر محیط کشت اشدون آگار محیط کشت اشدون آگار یک محیط کشت انتخابی برای[بیشتر بخوانید]
تست هیدرولیز کازئین: اصول، روش، کاربرد و تفسیر
مقدمهای بر تست هیدرولیز کازئین (Casein Hydrolysis) کازئین به عنوان پروتئین اصلی شیر، یک ماکرومولکول[بیشتر بخوانید]
بروسلا آگار (Brucella Agar): ترکیب، اصول، روش آمادهسازی، نتایج و کاربرد
مقدمهای بر بروسلا آگار بروسلا یک انگل درون سلولی است که باعث سقط جنینهای اپیزوتیک[بیشتر بخوانید]
اندو آگار (Endo Agar): ترکیب، اصول، روش آمادهسازی و کاربرد
مقدمهای بر اندو آگار (Endo Agar) اندو آگار توسط Endo جهت افتراق باکتریهای گرم منفی[بیشتر بخوانید]
4 دیدگاه